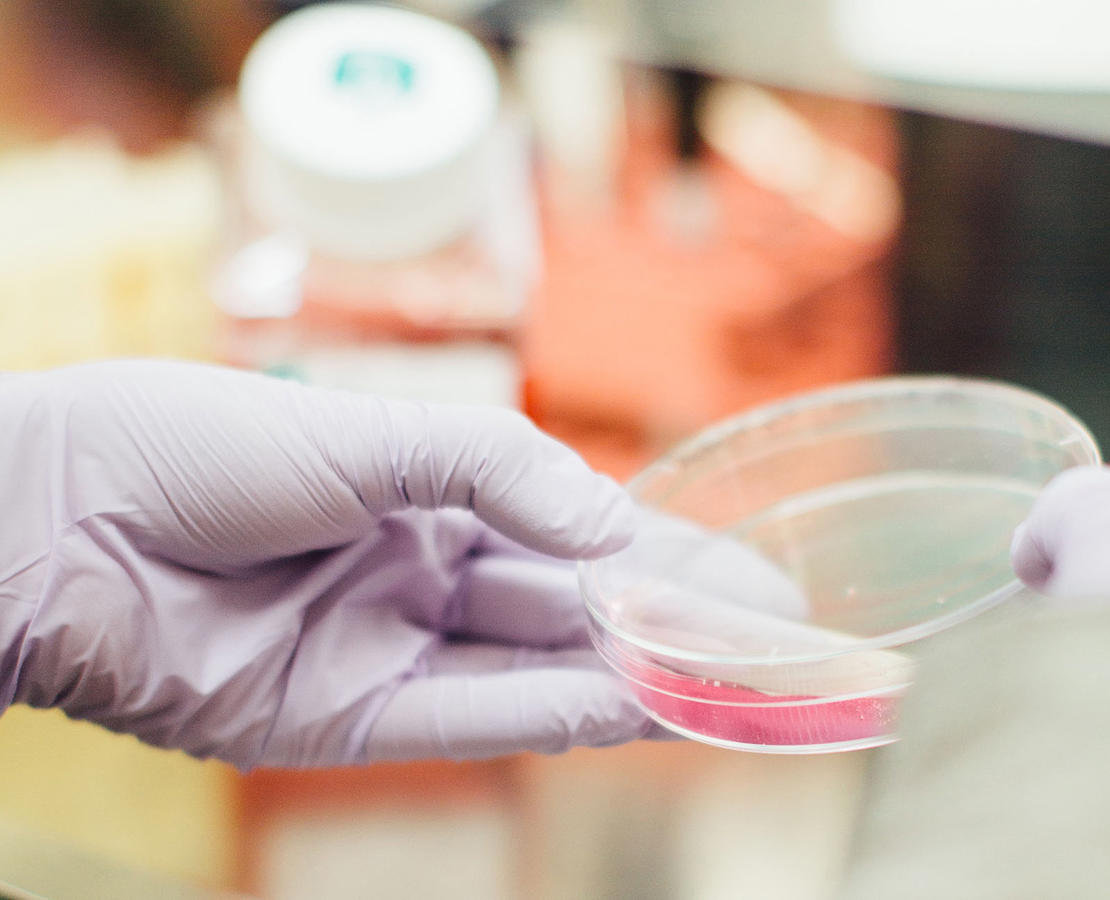

Infektioner
Læs artikler, nyheder om forskning i infektioner relateret til cystisk fibrose samt beskrivelser af de forskningsprojekter Cystisk Fibrose Foreningen har støttet inden for emnet.

Af Sigrid Hjermind, Cand. med. Cystisk Fibrose Center, Rigshospitalet, København. Præsenteret på den 40. europæiske Cystisk Fibrose Kongres i Sevilla, Spanien.

Tilbagevende infektioner i lungevævet hos CF-patienter resulterer i skade på lungevævet og faldende lungefunktion. Infektion medfører inflammation i lungevævet. Under inflammation frigives inflammatoriske markører. Ved bronkoalveolær lavage (BAL) ophentes materiale fra lungevæv ved at skylle med saltvand, og niveauer af inflammationsmarkører kan bestemmes i denne BAL-væske.
Multiple breath washout (MBW), hvor patienter indånder rent ilt, anvendes til at bestemme den tid, det tager at udvaske atmosfærisk kvælstof fra lungevævet, og her ud fra udregnes Lung Clearance Index (LCI). LCI-værdier kan anvendes som udtryk for graden af defekter i lungerne.
Vi har ønsket at finde ud af, om LCI-værdier afspejler niveauet af inflammationsmarkører i BAL-væske. Teorien er, at høje LCI-værdier er udtryk for inflammation og dermed høje niveauer af inflammationsmarkører. Ligeledes har vi undersøgt, om niveauet af inflammationsmarkører var signifikant højere ved fund af bakterier i BAL-væsken og ved fund af stigende LCI for den enkelte patient. Der er undersøgt for to typer inflammationsmarkører, som kaldes interleukin 1 beta (IL1beta)og interleukin 8 (IL8).
For IL1beta fandtes en signifikant sammenhæng med LCI. For de øvrige undersøgte inflammationsmarkører fandt vi ingen sammenhæng, ej heller ved fund af bakterier eller ved LCI-stigning.
Læs artikler, nyheder om forskning i infektioner relateret til cystisk fibrose samt beskrivelser af de forskningsprojekter Cystisk Fibrose Foreningen har støttet inden for emnet.
Du kan støtte Cystisk Fibrose Foreningen på flere måder: